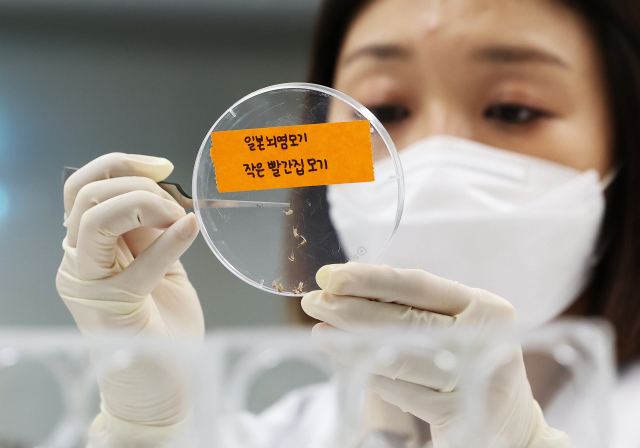

더위 먹고 주춤했던 모기, 더위 주춤하자 기지개
- 가
여름 모기 평년보다 20% 감소
30도 넘어가는 더위에 맥 못 춰
가을 모기 평년보다 늘며 기승 조짐
경기도보건환경연구원에서 연구원들이 모기 분류 작업을 하고 있다. 연합뉴스
경기도보건환경연구원에서 연구원들이 모기 분류 작업을 하고 있다. 연합뉴스
기록적인 폭염에 여름 모기 개체 수가 평년과 비교해 20% 가까이 줄어든 것으로 나타났다. 스스로 체온을 조절하지 못하는 모기가 폭염과 열대야가 길게 이어지며 버티지 못했다. 절기상 가을인 이달에도 열대야가 이어지지만, 기온이 떨어지면 모기가 기승을 부릴 가능성이 커 대비가 필요하다.
8일 질병관리청 감염병 포털에 따르면 지난 7~8월 사이 전국 11개 시도의 13개 지점 축사에서 채집된 전체 모기 개체 수는 4990마리였다. 이는 평년(2020~2022년) 같은 기간 평균이 5972마리였던 것과 비교해 20%쯤 줄어든 수치다.
모기는 변온동물인 만큼 높은 기온이 이어지면 대사 작용이 빨라져 수명이 줄어드는 특성이 있다. 기온이 30도가 넘어가면 모기는 거의 활동하지 않는다. 여름철 주요 모기 서식처인 물웅덩이나 개울도 폭염으로 말라붙으면서 모기가 잘 자랄 수 없는 환경도 조성됐다. 장마철 비도 계속 내리는 것이 아니라, 집중 호우 형태로 쏟아졌다가 금방 그친 점도 영향을 미쳤다.
가을로 접어들자 모기가 늘어나는 추세다. 가장 최근 집계치인 지난달 25~31일 채집된 모기 숫자는 725마리였다. 평년 평균치인 583마리보다 많다. 일본뇌염 매개 모기인 작은 빨간집 모기가 늘어난 영향도 있다. 올해 확인된 작은 빨간집 모기는 322마리로 평년의 같은 기간 171마리보다 2배 많다. 지난달 29일 올해 들어 처음으로 작은 빨간집 모기에 물린 일본뇌염 환자 2명이 동시에 확인되기도 했다.
올여름 모기가 유독 힘을 못 쓴 이유는 결국 폭염과 열대야 영향이다. 부산지방기상청에 따르면 올여름 부울경 평균기온은 25.9도로 평년의 24.1도보다 1.8도 높았고, 기상관측망을 전국적으로 확충한 1973년 이후 역대 1위를 기록했다.
올해 부울경 여름철 평균 폭염일수는 27.9일로 역대 3위, 열대야 일수는 23.5일로 역대 1위였다. 반면, 평균 강수량은 574.9mm로 평년의 772.9mm의 73.7% 수준에 불과했다.
부산기상청은 “올여름 부울경 기후 특성은 높은 기온과 열대야 기승, 장마철 집중 호우, 7월 하순 이후 적은 강수로 정리할 수 있다”고 밝혔다. 올여름 기록적인 폭염과 열대야로 사람도 견디기 어려웠지만, 모기도 견디기 어려웠던 셈이다.
조영미 기자 mia3@busan.com
당신을 위한 추천 기사
실시간 핫뉴스












